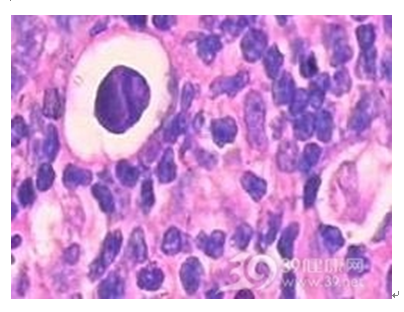

慢性淋巴结炎
慢性淋巴结炎简介
慢性淋巴结炎多继发于头、面、颈部的炎症病灶。淋巴结不同程度的肿大,散见于颈侧区或颌下、颏下区。可略硬但表面光滑,能活动,可有轻度压痛或不适。慢性淋巴结炎本人不需要治疗,检查时应注意寻找原发炎症灶。除颈部各区外还应仔细检查头皮、外耳及口腔、扁桃体、牙龈等隐藏部位。还可按肿大淋巴结的淋巴接纳区找寻原发病灶。
慢性淋巴结炎有哪些症状?
向您详细介绍慢性淋巴结炎症状,尤其是慢性淋巴结炎的早期症状,慢性淋巴结炎有什么表现?得了慢性淋巴结炎会怎样?
慢性淋巴结炎症状
早期症状: 局部淋巴结肿大,最初在常见部位,如:颌下、颏下、颈深上淋巴结肿大、压痛、周界清、活动无粘连。
晚期症状: 病情继续发展,淋巴结炎症波及周围组织时,淋巴结触诊不活动,疼痛加剧,进一步发展为腺源性蜂窝织炎。
相关症状: 口腔黏膜溃疡 腋区疼痛 透明血管型
一、症状
局部淋巴结肿大,最初在常见部位,如:颌下、颏下、颈深上淋巴结肿大、压痛、周界清、活动无粘连。病情继续发展,淋巴结炎症波及周围组织时,淋巴结触诊不活动,疼痛加剧,进一步发展为腺源性蜂窝织炎。
慢性淋巴结炎有反复消胀史,2—3个淋巴结,质中等硬度,活动、压痛。
二、诊断
根据病史、临床症状和实验室检查资料可以诊断。
慢性淋巴结炎是怎么回事?
向您详细介绍慢性淋巴结炎的病理病因,慢性淋巴结炎主要是由什么原因引起的。
慢性淋巴结炎病因 主要病因: 金黄色葡萄球菌、溶血性链球菌致
病因
各种牙源性感染、颌骨炎症、口腔粘膜感染和溃疡,扁桃体炎和咽炎、耳、鼻、喉、眼及皮肤涎腺等的感染。
慢性淋巴结炎可能并发哪些疾病?
向您详细介绍慢性淋巴结炎有哪些并发病症,慢性淋巴结炎还会引起哪些疾病?
慢性淋巴结炎并发症
常见并发症: 蜂窝织炎
可进一步发展为腺源性蜂窝织炎。
慢性淋巴结炎应该如何预防?
向您详细介绍慢性淋巴结炎应该如何预防,常见预防措施有哪些。
慢性淋巴结炎预防
注意个人卫生,提高身体素质,防止各种牙源性感染、颌骨炎症、口腔粘膜感染和溃疡,扁桃体炎和咽炎、耳、鼻、喉、眼及皮肤涎腺等的感染而引发此病。
慢性淋巴结炎如何鉴别?
向您详细介绍慢性淋巴结炎应该如何鉴别诊断。
结核性淋巴结炎
有发热、多汗、乏力、血沉增快,多见于青壮年。常伴发肺结核,淋巴结质地不均匀,有的部分较轻(干酪样变),有的部分较硬(纤维化或钙化),且互相粘连,并和皮肤粘连,所以活动度差。这类患者结核菌素实验和血中结核抗体阳性。
恶性淋巴瘤
也可见于任何年龄组,其淋巴结肿大常为无痛性、进行性肿大,可从黄豆大到枣大,中等硬度。一般与皮肤无粘连,在初、中期相互不融合,可活动。到了后期淋巴结可长到很大,也可融合成大块,直径达20cm以上,侵犯皮肤,破溃后经久不愈。此外,可侵犯纵隔、肝、脾及其它器官,包括肺、消化道、骨骼、皮肤、乳腺、神经系统等。确诊需活组织病理检查。临床上恶性淋巴瘤常易误诊,以表浅淋巴结肿大为首发表现者,有70%~80%在初诊时被确诊为淋巴结炎或淋巴结结核,以致延误治疗。
巨大淋巴结增生
是一种易误诊的罕见病。常表现为原因不明的淋巴结肿大,主要侵犯胸腔,以纵隔最多,也可侵犯肺门及肺内。其它受侵部位有颈部、腹膜后、盆腔、腋窝以及软组织。常易误诊为胸腺瘤、浆细胞瘤、恶性淋巴瘤等。了解本病的病理及临床表现对早期诊断极为重要。
假性淋巴瘤
常发于淋巴结外的部位,如眼眶、胃的假性淋巴瘤及消化道的淋巴性息肉,均可形成肿块。一般认为属反应性的增生,由炎症引起。
淋巴结转移瘤
淋巴结常较硬,质地不均匀,可找到原发灶。很少为全身性淋巴结肿大。
慢性淋巴结炎怎样治疗?
向您详细介绍慢性淋巴结炎的治疗方法,治疗慢性淋巴结炎常用的西医疗法和中医疗法。慢性淋巴结炎应该吃什么药。
慢性淋巴结炎诊疗知识
就诊科室: 内分泌科 治疗费用: 不同医院收费标准不一致,市三甲医院约(500-1000元) 治愈率: 治疗周期: 治疗方法: 药物治疗、手术治疗
慢性淋巴结炎一般治疗
一、全身治疗。
1.急性淋巴结炎应首先控制炎症,避免扩散,选用有效足量的抗生素如青、链霉素或其他广谱抗生素,亦可根据标本的药敏试验选择用药。
2.结核性淋巴结炎,可选用异烟肼lOOmg,每日3次,长期使用18—24个月,链霉素0.5g,每日2次肌注。
3.支持疗法:补充必要的维生素及液体,调节电解质平衡。
二、局部治疗。
1.外敷消炎散以消炎止痛。
2.敷贴,结核性淋巴结炎如有穿破成瘘,可在切除窦道刮除病变组织的基础上,用链霉素敷贴。
3.封闭疗法:脓肿尚未形成时可用青霉素、普鲁卡因溶液做淋巴结周围封闭(需先做皮试)。
三、手术治疗。
1.化脓性淋巴结已伴有口底间隙脓肿或蜂窝织炎时,应作切开引流术,以排除脓液及坏死组织。
2.对抗结核药物治疗效果不佳的单个或活动增殖性淋巴结结核,可采用手术切除并作病理检查。
慢性淋巴结炎辨证论治
慢性淋巴结炎属中医“脊核”范畴。痈的发病原因为外感风温,风热挟痰蕴结少阳.阳明之络;或因肝胃之火毒上炎,挟痰凝结;或下肢.阴部破碎感染,毒邪循经继发为胯腹痈;或因湿热下注,壅而不行;亦可因冻疮.足跟皲裂.足癣.湿疹等感染毒邪,以致湿热蕴阻,经络阻隔,气血凝滞所致。治疗原则拟清热解毒.化痰消肿为主,并根据发病部位和不同阶段进行辨证施治。
慢性淋巴结炎就诊指南
慢性淋巴结炎就诊指南针对慢性淋巴结炎患者去医院就诊时常出现的疑问进行解答,例如:慢性淋巴结炎挂什么科室的号?慢性淋巴结炎检查前的注意事项?医生一般会问什么?慢性淋巴结炎要做哪些检查?慢性淋巴结炎检查结果怎么看?等等。慢性淋巴结炎就诊指南旨在方便慢性淋巴结炎患者就医,解决慢性淋巴结炎患者就诊时的疑惑问题。
典型症状
口腔黏膜溃疡、腋区疼痛、透明血管型
建议就诊科室
内分泌科
最佳就诊时间
无特殊,尽快就诊
就诊时长
初诊预留1天,复诊每次预留半天
复诊频率/诊疗周期
门诊治疗:每周复诊至逐步拉长复诊周期发热减轻后,不适随诊。 严重者需入院治疗待疼痛减少后转门诊治疗。
就诊前准备
无特殊要求,注意休息。
常见问诊内容
1、描述就诊原因(从什么时候开始,有什么不舒服?)
2、不适的感觉是否由明显的因素引起?
3、有发热、压痛等伴随症状?
4、是否到过医院就诊,做过那些检查,检查结果是什么?
5、治疗情况如何?
6、有无药物过敏史?
重点检查项目
1.涂片
涂片是检测血液中或者组织中的包括淋球菌、新型隐球菌、梅毒螺旋体、白喉棒状杆菌等病原体的一种检查方法。
2.血常规
血常规是最一般,最基本的血液检验。血常规检查一般取用末梢血检查,如指尖、耳垂部位的血。在经过血液细胞分析仪器,电脑报告结果,此项目已成为检查病人的一个惯例。血液由液体和有形细胞两大部分组成,血常规检验的是血液的细胞部分。血液有三种不同功能的细胞——红细胞(俗称红血球),白细胞(俗称白血球)、血小板。通过观察数量变化及形态分布,判断疾病。是医生诊断病情的常用辅助检查手段之一。
3.局部淋巴显象
局部淋巴显像可提供局部引流淋巴结的空间分布及位置,这有助于恶性肿瘤放射治疗布野的实施,由此提高放射治疗布野的准确性及肿瘤的治愈率。
诊断标准
根据患者临床表现、体征和辅助检查结果通常可明确诊断,尤其是存在原发感染病灶时。注意除外其他引起淋巴结肿大的疾病,必要时可行淋巴结病理活检检查帮助确诊。
慢性淋巴结炎应该做哪些检查?
向您详细介慢性淋巴结炎应该做哪些检查,常用的慢性淋巴结炎检查项目有哪些。
慢性淋巴结炎常见检查
|
检查名称 |
检查部位 |
检查科室 |
检查作用 |
|
涂片 |
全身 |
皮肤 保健科 特需病房 |
涂片作用为检... |
|
头颅平片 |
头部 |
核医学 |
头颅平片用于... |
|
局部淋巴显象 |
淋巴 |
超声室 |
局部淋巴显像... |
|
普通透视检查 |
全身 |
放射科 |
普通透视检查... |
1.涂片
涂片是检测血液中或者组织中的包括淋球菌、新型隐球菌、梅毒螺旋体、白喉棒状杆菌等病原体的一种检查方法。
2.血常规
血常规是最一般,最基本的血液检验。血常规检查一般取用末梢血检查,如指尖、耳垂部位的血。在经过血液细胞分析仪器,电脑报告结果,此项目已成为检查病人的一个惯例。血液由液体和有形细胞两大部分组成,血常规检验的是血液的细胞部分。血液有三种不同功能的细胞——红细胞(俗称红血球),白细胞(俗称白血球)、血小板。通过观察数量变化及形态分布,判断疾病。是医生诊断病情的常用辅助检查手段之一。
3.局部淋巴显象
局部淋巴显像可提供局部引流淋巴结的空间分布及位置,这有助于恶性肿瘤放射治疗布野的实施,由此提高放射治疗布野的准确性及肿瘤的治愈率。
慢性淋巴结炎应该如何护理?
向您详细介绍慢性淋巴结炎应该如何护理,慢性淋巴结炎常见的护理办法有哪些。
慢性淋巴结炎一般护理
①、保持乐观愉快的情绪。长期出现精神紧张、焦虑、烦燥、悲观等情绪,会使大脑皮质兴奋和抑制过程的平衡失调,所以需要保持愉快的心情。
②、生活节制注意休息、劳逸结合,生活有序,保持乐观、积极、向上的生活态度对预防疾病有很大的帮助。做到茶饭有规律,生存起居有常、不过度劳累、心境开朗,养成良好的生活习惯。
③、合理膳食可多摄入一些高纤维素以及新鲜的蔬菜和水果,营养均衡,包括蛋白质、糖、脂肪、维生素、微量元素和膳食纤维等必需的营养素,荤素搭配,食物品种多元化,充分发挥食物间营养物质的互补作用,对预防此病也很有帮助。
慢性淋巴结炎吃什么好?
向您详细介绍慢性淋巴结炎饮食保健,慢性淋巴结炎的食疗方。得了慢性淋巴结炎吃什么好,同时又不能吃什么呢?
慢性淋巴结炎饮食宜忌
饮食适宜:1.宜吃具有消炎作用的食物;2.宜吃寒凉性的食物;3.宜吃具有增加免疫功能的食物。
|
宜吃食物 |
宜吃理由 |
食用建议 |
|
核桃 |
含有丰富的DHA以及不饱和脂肪酸,可增加机体的免疫力,促进炎症的恢复。 |
2-5个每天,直接食用。 |
|
牛初乳 |
含有初乳蛋白以及免疫球蛋白,可增加机体的免疫功能。 |
250毫升每天。 |
|
折耳根 |
维生素、纤维素含量丰富,可改善机体的免疫功能。 |
150g清炒食用。 |
饮食禁忌:1.忌吃温热性的食物;2.忌吃燥性的食物;3.忌吃酸性大的食物。
|
忌吃食物 |
忌吃理由 |
忌吃建议 |
|
柠檬 |
酸性的食物,特别对于口腔的淋巴结炎是绝对禁忌的,可诱发加重疼痛。 |
可吃酸性小的西红柿。 |
|
狗肉 |
属于温补性的食物,对于肿瘤性疾病,可造成肿瘤的进行性增大。 |
换吃无燥热性的鱼肉。 |
|
腌酱菜 |
属于温热壮阳的食物,对于本病而言不宜食用。 |
可吃清淡的白菜。 |
慢性淋巴结炎饮食原则
食疗方:(资料仅参考,具体请询问医生)
1、蒲公英粥:蒲公英30g(鲜者加倍),大米100g,白糖适量。将蒲公英择净,放入锅中,加清水适量,浸泡5"t0分钟后,水煎取汁,加大米煮粥。或将鲜蒲公英择洗干净,切细,待粥熟时调入粥中,纳入白糖,再煮一、二沸即成。每日1剂,连续3-5天。可清热解毒,消肿散结。适用于淋巴结炎肿胀疼痛,质硬易移动等。
2、鱼腥草粥:鱼腥草30g(鲜者加倍),大米lOOg,白糖适量。将鱼腥草择净,放人锅中,加清水适量,浸泡5"t0分钟后,水煎取汁,加大米煮粥,或将鲜鱼腥草择洗干净,切细,待粥熟时调入粥中,纳入白糖,再煮一、二沸即成。每日1剂,连续3"-5天。可清热解毒。适用于淋巴结炎肿痛,质硬压痛等。
3、穿心莲粥:穿心莲lOg,大米lOOg,调味品适量。将穿心莲择洗干净,放人锅中,加清水适量,浸泡5-10分钟后,水煎取汁,加大米煮粥,待熟时调入食盐等调味品,再煮一、二沸即成。每日1-2剂,连续3--5天。可清热解毒,消肿散结。适用于淋巴结炎肿胀疼痛,口干口苦等。
4、野菊花粥:野菊花lOg,大米lOOg,白糖适量。将野菊花择净,放人锅中,加清水适量,水煎取汁,加大米煮粥,侍熟时调人白糖,再煮一、二沸即成。每日1^2剂,连续3---5天。可清热解毒,消肿散结。适用于淋巴结炎肿胀疼痛,头目昏花,视物模糊等。
5、牡蛎雪菜汤:牡蛎、雪菜、调味品各适量。将雪菜发开、洗净;牡蛎去壳、取肉。锅中放清水适量煮沸后,下葱、姜、椒、料酒、米醋等,再下雪菜、牡蛎煮熟后,食盐、味精调味服食。每日l-2剂,连续7--10天。可散结止痛。适用于淋巴结炎肿痛,质硬压痛等。
6、牡蛎粥:牡蛎、大米、调味品各适量。将牡蛎去壳、取肉,洗净,切细。先取牡蛎壳水煎取汁,再用药汁与大米煮粥,待沸时下牡蛎肉,煮至熟时,下葱、姜、椒、料酒、米醋、食盐、味精等,再煮一、二沸即成。每日l^2剂,连续7---10天。可散结止痛。适用于淋巴结炎肿痛,质硬压痛等。
7、芋头贝母粥:芋头50g,大米lOOg,贝母5g,白糖适量。将贝母研为细末备用。芋头择净,切为小块,大米淘净,同放入锅内,加清水适量煮粥,待熟时调入贝母粉、白糖,再煮一、二沸服食。每日1剂,7天为1疗程,连续2---3个疗程。可健脾胃,消瘰疬。适用于淋巴结炎肿痛,质硬压痛等。
8、芋头海带粥:芋头50g,海带、大米各lOOg,调味品适量。将海带洗净,切细;芋头择净,切为小块。大米淘净,三者同放入锅内,加清水适量煮粥,待熟时调入食盐等调味品,再煮一、二沸服食。每日1剂,7天为1疗程,连续2--3个疗程。可健脾消积。适用于淋巴结炎肿痛,质硬压痛等。
9、淡莱豆芽汤:淡菜、海藻各50g,黄豆芽200g,调味品适量。把淡菜、海藻洗净,黄豆芽洗净去须根,姜切片,葱切段。炒锅置武火上烧热,加入素油,烧六成熟时,加入姜、葱爆香,加清水1000mL,武火烧沸,文火炖煮45分钟加盐即成。每日1次,连续7-10天。可健脾消积。适用于淋巴结炎肿痛,质硬压痛,大便秘结等。
1 0、淡菜粥:淡菜30g,大米lOOg,调味品适量。将淡菜发开,洗净,大米淘净,加清水适量煮粥,待沸后下淡菜,煮至粥熟后,下调味品,再煮一、二沸即成。每日l剂,连续7---10天。可散结消肿。适用于淋巴结炎肿痛,质硬压痛等。
11、凉拌海蜇:海蜇、调味品各适量。将海蜇发开,洗净,切丝,放沸水锅中煮熟后,取出,用葱、姜椒、蒜、香麻油、食盐等拌匀服食。每日1剂,连续7~10天。可清热化痰,软坚散结。适用于淋巴结炎肿痛,质硬压痛等。
12、榨菜肉丝汤:榨菜、西红柿、猪瘦肉、调味品各适量。将榨菜、西红柿洗净。切细;猪瘦肉洗净,切丝,勾芡。锅中放清水适量烧沸后,下榨菜、瘦肉、西红柿、葱姜等调味品等,煮熟即成。每日1—2剂。可软坚散结。适用于淋巴结炎肿痛,质硬压痛等。
13、夏枯草30g,绿豆30g,水煮取汁,加适量白糖,每日1剂,日2次。或用鲜蒲公英50g,鲜夏枯草50g,水煮取汁,加适量白糖调味,每日1剂,日2次。
患者吃什么好?
饮食宜清淡,营养宜均衡。
患者不适宜吃什么?
忌食辛辣刺激食品。
如何治疗慢性淋巴结炎 慢性淋巴结炎如何护理 慢性淋巴结炎的并发症 更多疾病食疗方法
温馨提示:以上资料仅提供参考,具体情况请向医生详细咨询。



